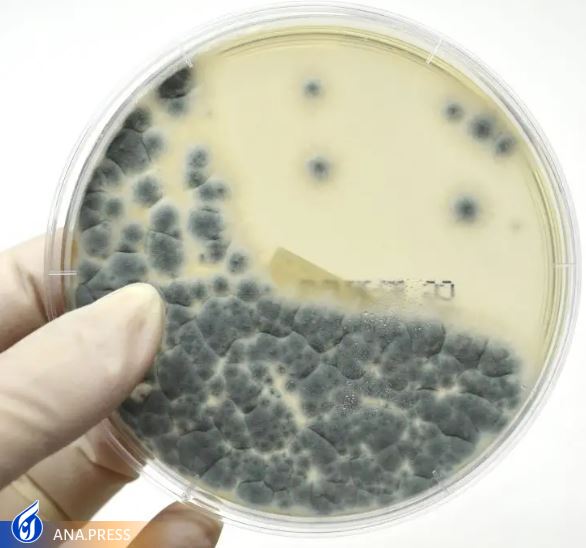
مراقب قارچهای موجود در آرد باشید مراقب قارچهای موجود در آرد باشید

مراقب قارچهای موجود در آرد باشید
به گزارش گروه دانش و فناوری خبرگزاری آنا به نقل از وبگاه (سای تک دیلی)، در سریال HBO"The Last of Us" که به نام بازی ویدیویی محبوب با همین نام نامگذاری شده است، ذخایر آرد جهان به قارچی به نام Cordyceps آلوده شده است. وقتی مردم پنکیک یا سایر غذاهای تهیه شده با آن آرد را میخورند، قارچها در داخل بدن آنها رشد میکنند و آنها را به زامبی تبدیل میکنند.
من به عنوان یک دانشمند مواد غذایی، تأثیر فرآوری را بر کیفیت و ایمنی میوهها و سبزیجات، از جمله آرد مورد استفاده برای تهیه پنکیک، مطالعه میکنم. در حالی که هیچ کس با خوردن پنکیک در زندگی واقعی به زامبی تبدیل نمیشود، آرد اغلب با قارچهایی آلوده است که میتواند مایکوتوکسینهایی تولید کند که افراد را بیمار میکند. با این حال، پردازش و پخت مناسب به طور کلی میتواند شما را ایمن نگه دارد.
** قارچ در آرد چقدر رایج است؟
مردم حدود ۱۴۰۰۰ سال است که از نان گندم میخورند و حداقل ۱۰۰۰۰ سال است که گندم کشت میکنند. در سال ۱۸۸۲، "بیماری نان مست" برای اولین بار در روسیه ثبت شد، جایی که مردم پس از خوردن نان سرگیجه، سردرد، لرزش دست، گیجی و استفراغ را گزارش کردند. مدتها قبل از آن، دهقانان چینی گزارش میدادند که خوردن گندم صورتی - یکی از نشانههای کلیدی عفونت با کپکی به نام فوزاریوم - باعث میشود آنها احساس بیماری کنند. واضح است که قارچها برای مدت طولانی مردم را بیمار میکنند.
گندم، ذرت، برنج و حتی میوهها و سبزیجات میتوانند با رشد قارچها در مزرعه آلوده شوند. در «آخرین ما»، یک اپیدمیولوژیست این نظریه را مطرح میکند که تغییرات آب و هوایی باعث جهش قارچ میشود تا بتواند انسانها را آلوده کند. واقعیت تاسفبار این است که قارچها در سالهای اخیر با افزایش دما، به یک مشکل تبدیل شدهاند.
یک مطالعه در سال ۲۰۱۷ نشان داد که بیش از ۹۰ درصد از نمونههای آرد گندم و ذرت در واشنگتن دی سی حاوی قارچهای زنده بودند که Aspergillus و Fusarium انواع غالب کپکها در آرد گندم بودند. فوزاریوم روی گندم در مزرعه رشد میکند و میتواند یک بیماری رایج گیاهی کشاورزی به نام بیماری فوزاریوم سر یا دلمه ایجاد کند.
کشاورزان از تکنیکهای متعددی برای کاهش این بیماری ویرانگر گیاهی استفاده میکنند، از جمله اجرای تناوب زراعی، استفاده از ارقام مقاوم و قارچ کشها و به حداقل رساندن آبیاری در زمان گلدهی. پس از برداشت، دانهها را مرتب میکنند تا گندمهای آلوده را قبل از آسیاب کردن به آرد از بین ببرند. در حالی که مرتب سازی بیشتر گندم آلوده را حذف میکند، مقدار کمی قارچ همچنان میتواند آن را به آرد تبدیل کند.
آسپرژیلوس یکی از کپکهای غالب موجود در آرد گندم است.
** از بین بردن میکروارگانیسمهای موجود در آرد
خبر خوب این است که بیشتر قارچها و سایر میکروارگانیسمها در دمای ۱۶۰-۱۷۰ درجه فارنهایت (۷۱-۷۷ درجه سانتیگراد) میمیرند. پنکیکها معمولاً در دمای داخلی ۱۹۰-۲۰۰ درجه فارنهایت (۸۸-۹۳ درجه سانتیگراد) پخته میشوند. سایر کیکها و نانها در دمای داخلی از ۱۸۰ تا ۲۱۰ درجه فارنهایت (۸۲ تا ۹۹ درجه سانتیگراد) پخته میشوند. بنابراین، برخلاف فیلم The Last of Us، تا زمانی که خمیر خود را بپزید یا سرخ کنید، قارچها را از بین خواهید برد.
مشکل زمانی پیش میآید که مردم آرد را بدون پختن اول میخورند، مثلاً با مصرف خمیر شیرینی خام یا "لیسیدن کاسه تمیز". هم تخم مرغ خام و هم آرد خام میتوانند حاوی میکروارگانیسمهایی باشند که افراد را بیمار میکند. میکروارگانیسمهایی که مقامات بهداشت عمومی بیش از همه نگران آن هستند، E. coli و Salmonella هستند، پاتوژنهای خطرناکی که میتوانند باعث بیماری شدید شوند.
اکثر مردم نمیدانند که آردی که در فروشگاه میخرند، آرد خامی است که هنوز حاوی میکروارگانیسمهای زنده است. آرد به ندرت به عنوان خام مصرف میشود، زیرا مصرف کنندگان تقریباً همیشه غذاهای مبتنی بر آرد را طبخ میکنند. در حالی که مصرف کنندگان میتوانند آرد خام را در خانه حرارت دهند، اما این کار توصیه نمیشود، زیرا ممکن است آرد به اندازه کافی نازک پخش نشود تا همه میکروارگانیسمها را از بین ببرد.
برخی از قارچها و میکروارگانیسمها میتوانند هاگ ایجاد کنند، که مانند دانههایی هستند که به آنها کمک میکند در شرایط نامطلوب زنده بمانند. این هاگها میتوانند در پختن، خشک شدن و انجماد زنده بمانند. حتی هاگهای مخمر ۴۵۰۰ ساله نیز وجود دارد که دوباره بیدار شده و به نان تبدیل شده است. این هاگهای قارچی به ندرت باعث بیماری جدی در افراد میشوند، به جز در افرادی که سیستم ایمنی ضعیفی دارند.
برای جلوگیری از رشد قارچ میتوان مواد شیمیایی را به غذا اضافه کرد. این افزودنیها شامل سوربات ها، بنزواتها و پروپیوناتها هستند. با این حال، تقریباً هرگز این مواد افزودنی را در مخلوط آرد یا پنکیک نمیبینید، زیرا قارچها نمیتوانند در پودر خشک رشد کنند. قارچها یا روی گندم در مزرعه رشد کردند یا بعد از پختن روی نان. به همین دلیل، ممکن است این افزودنیها را در نان ببینید، اما در مخلوط پودری مشاهده نکنید.

شاید بهتر باشد آن نان کپک زده را به حال خود رها کنید.
** مایکوتوکسینها
بزرگترین خطر قارچ این نیست که در داخل بدن ما رشد کند، بلکه این است که روی گندم یا سایر غذاها رشد میکند و مواد شیمیایی به نام مایکوتوکسین تولید میکند که میتواند باعث مشکلات شدید سلامتی شود. هنگامی که گندم برداشت میشود و به آرد تبدیل میشود، مایکوتوکسینها میتوانند با آن مخلوط شوند.
متأسفانه، در حالی که پخت و پز معمولی میتواند میکروارگانیسمها را از بین ببرد، مایکوتوکسینها را از بین نمیبرد. خوردن مایکوتوکسینها میتواند باعث ایجاد مشکلاتی از توهم تا استفراغ و اسهال تا سرطان یا مرگ شود. برخی از مایکوتوکسینهای رایج موجود در غلات عبارتند از آفلاتوکسین، دئوکسی نیوالنول، اکراتوکسین A و فومونیزین B.
قدیمیترین مورد شناخته شده مسمومیت با مایکوتوکسین به عنوان بیماری به نام ارگوتیسم ثبت شده است. ارگوتیسم در عهد عتیق ذکر شده است و از سال ۸۰۰ پس از میلاد در اروپای غربی گزارش شده است. حتی گفته شده است که محاکمههای جادوگر سالم به دلیل شیوع ارگوتیسم که قربانیان آن را به توهم میبرد، ایجاد شده است، اگرچه بسیاری این ایده را رد کرده اند. گندم کمتر از سایر غلات دارای مایکوتوکسینهای خطرناک است، به همین دلیل است که برخی معتقدند کاهش مرگ و میر در اروپای قرن ۱۸، به ویژه در انگلستان، به دلیل تغییر رژیم غذایی مبتنی بر چاودار به رژیم غذایی مبتنی بر گندم بوده است.
در نهایت، لازم نیست نگران خوردن آن پنکیک باشید. کشاورزان از تکنیکهای زیادی برای به حداقل رساندن رشد قارچ و حذف دانههای کپک زده استفاده میکنند و دولت در طول تولید و ذخیره سازی محصولات، سطوح مایکوتوکسین را زیر نظر دارد. فقط مطمئن شوید که محصولات نانوایی خود را قبل از غذا میپزید و چیزی که شروع به کپک زدن کرده است نخورید.
انتهای پیام/